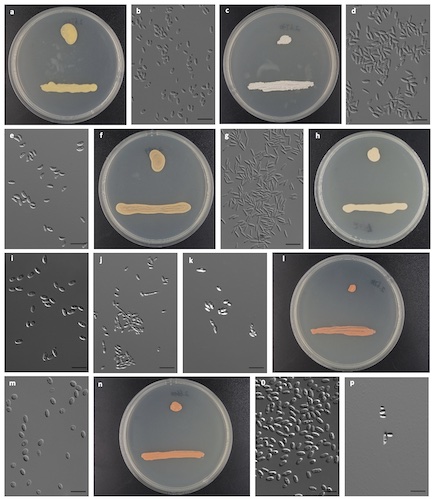
The hidden taxonomic novelty of anamorphic basidiomycetous yeasts in the phyllosphere and tidal flats in China

Research
Research in the Stajich lab encompass a variety of topics from Evolution, Genomics, Mycology, Microbiology, and Bioinformatics.
All
2026
A long non-coding RNA regulates in vitro and in vivo triazole antifungal susceptibility in Aspergillus fumigatus
GENETICS
·
15 Jun 2026
·
doi:10.1093/genetics/iyag152
An epigenetic mechanism of azole tolerance facilitates acquired antifungal resistance in Aspergillus fumigatus
mBio
·
15 Jun 2026
·
pmid:42294675
Novel Glomeromycotina-moss associations identified in California dryland biocrusts.
The New phytologist
·
04 May 2026
·
pmid:42083270
Effects of environmental setting and diet on the gut microbial ecology of eastern hellbenders (Cryptobranchus alleganiensis alleganiensis).
Animal microbiome
·
16 Apr 2026
·
pmid:41992364

Evolution of a chloroplast subcompartment housing plastid DNA inside a cup-like starch granule.
Current biology : CB
·
02 Apr 2026
·
pmid:41932335
Genomic and Ecological Flexibility Shape the Global Distribution of a Black Fungus.
Environmental microbiology
·
01 Apr 2026
·
pmid:41958070

Phyling: phylogenetic inference from annotated genomes.
G3 (Bethesda, Md.)
·
26 Mar 2026
·
pmid:41885611
Thermal adaptation crosstalk with azole response through lncRNA in Aspergillus fumigatus
bioRxiv : the preprint server for biology
·
20 Mar 2026
·
pmid:41890020

Manipulation of Global Regulator mcrA Activates the Fumigermin Pathway in Penicillium camemberti IMV00769
ACS chemical biology
·
11 Feb 2026
·
pmid:41670438

Inferring fungal cis-regulatory networks from genome sequences via unsupervised and interpretable representation learning.
Genetics
·
07 Jan 2026
·
pmid:41022589
2025

Morphological and genetic characterization of novel Sarocladium spinificis strains in association with Coccidioides posadasii
Microbiology spectrum
·
29 Dec 2025
·
pmid:41459970
The hidden taxonomic novelty of anamorphic basidiomycetous yeasts in the phyllosphere and tidal flats in China
Mycosphere
·
22 Dec 2025
·
doi:10.5943/mycosphere/16/1/27

A haplotype-resolved chromatin landscape connects cis-regulatory variants to trait variation in Citrus.
BMC genomics
·
30 Oct 2025
·
pmid:41168720

Genome annotation of
Aspergillus melleus
strain CBS 546.65
Microbiology Resource Announcements
·
09 Oct 2025
·
doi:10.1128/mra.00519-25

Coordinated regulation of Mdr1- and Cdr1-mediated protection from antifungals by the Mrr1 transcription factor in emerging
mBio
·
07 Oct 2025
·
pmid:41055359
A roadmap for equitable reuse of public microbiome data.
Nature microbiology
·
26 Sep 2025
·
pmid:41006832

Soil drivers of fungal, bacterial and plant diversity in contaminated Southern Californian sites: Implications for dryland bioremediation.
The Science of the total environment
·
06 Sep 2025
·
pmid:40915141

Dynamic remodeling of centrioles and the microtubule cytoskeleton in the lifecycle of chytrid fungi.
Molecular biology of the cell
·
20 Aug 2025
·
pmid:40833813

Kingdom-wide CRISPR guide design with ALLEGRO.
Nucleic acids research
·
11 Aug 2025
·
pmid:40829801

Celebrating the fifth edition of the International Symposium on Fungal Stress – ISFUS, a decade after its 2014 debut
Fungal Biology
·
01 Aug 2025
·
doi:10.1016/j.funbio.2025.101590

Draft genome of Conoideocrella luteorostrata ARSEF 14590 (Clavicipitaceae), an entomopathogenic fungus with a wealth of biosynthetic and biocontrol potential
Microbiology Resource Announcements
·
23 Jul 2025
·
doi:10.1128/mra.01273-24

Draft genome sequence of an uncultured archaeon from Antarctic endolithic communities
Microbiology Resource Announcements
·
23 Jul 2025
·
doi:10.1128/mra.00427-25

Comparative Genomics Reveals Intra and Inter Species Variation in the Pathogenic Fungus
Batrachochytrium dendrobatidis
Genome Biology and Evolution
·
30 May 2025
·
doi:10.1093/gbe/evaf114

Giant transposons promote strain heterogeneity in a major fungal pathogen.
mBio
·
12 May 2025
·
pmid:40353686

A Novel Sarocladium spinificis Strain Suppresses Coccidioides posadasii Growth Morphological and Genetic Perspectives
openRxiv
·
31 Mar 2025
·
doi:10.1101/2025.03.31.646452

Activation of the Trichodimerol Pathway through Deletion of mcrA in Marine Penicillium rubens YAP001
ACS chemical biology
·
17 Mar 2025
·
pmid:40097246

Increased aridity is associated with diversity and composition changes in the biocrust mycobiome
openRxiv
·
05 Mar 2025
·
doi:10.1101/2025.03.05.641731

Eukaryotic MAGs recovered from deep metagenomic sequencing of the seagrass, Zostera marina, include a novel chytrid in the order Lobulomycetales
openRxiv
·
11 Feb 2025
·
doi:10.1101/2025.02.11.637735

Fungal impacts on Earth’s ecosystems
Nature
·
05 Feb 2025
·
doi:10.1038/s41586-024-08419-4

Assessing the Evolutionary Trajectory of Arbuscular Mycorrhizal Conserved Genes in Seagrasses and Aquatic Close Relatives
openRxiv
·
25 Jan 2025
·
doi:10.1101/2025.01.23.634575

Absolute abundance unveils Basidiobolus as a cross-domain bridge indirectly bolstering gut microbiome homeostasis
The ISME journal
·
02 Jan 2025
·
pmid:40689579

Section-level genome sequencing and comparative genomics of Aspergillus sections Cavernicolus and Usti
Studies in Mycology
·
01 Jan 2025
·
doi:10.3114/sim.2025.111.03
2024

Novel Glomeromycotina-Moss Associations Identified in California Dryland Biocrusts
openRxiv
·
28 Dec 2024
·
doi:10.1101/2024.12.27.630416

Rhinocladiella similis: A Model Eukaryotic Organism for Astrobiological Studies on Microbial Interactions with Martian Soil Analogs
JACS Au
·
23 Dec 2024
·
doi:10.1021/jacsau.4c00869
Genomic streamlining of seagrass-associated Colletotrichum sp. may be related to its adaptation to a marine monocot host
openRxiv
·
17 Dec 2024
·
doi:10.1101/2024.12.17.629027

A genomic resource for exploring bacterial-viral dynamics in seagrass ecosystems
openRxiv
·
06 Dec 2024
·
doi:10.1101/2024.12.06.627215

Familiar fungal friends and foes
Current Biology
·
01 Dec 2024
·
doi:10.1016/j.cub.2024.11.005

Draft genome sequences for Neonectria magnoliae and Neonectria punicea, canker pathogens of Liriodendron tulipifera and Acer saccharum in West Virginia
Microbiology resource announcements
·
27 Nov 2024
·
pmid:39601523

A Cluster of Diutina catenulata Funguria in Patients with Coronavirus Disease 2019 (COVID-19) Hospitalized in a Tertiary Reference Hospital from Rio de Janeiro, Brazil
Current microbiology
·
03 Sep 2024
·
pmid:39223407

Description of new micro-colonial fungi species Neophaeococcomyces mojavensis, Coniosporium tulheliwenetii, and Taxawa tesnikishii cultured from biological soil crusts
openRxiv
·
13 Jun 2024
·
doi:10.1101/2024.06.12.598762

Prevalence and diversity of TAL effector-like proteins in fungal endosymbiotic
Microbial genomics
·
01 Jun 2024
·
pmid:38860878

Genomic and morphological characterization of Knufia obscura isolated from the Mars 2020 spacecraft assembly facility.
Scientific reports
·
28 May 2024
·
pmid:38806503

Study of fungal cell wall evolution through its monosaccharide composition: An insight into fungal species interacting with plants.
Cell surface (Amsterdam, Netherlands)
·
25 May 2024
·
pmid:38873189

Signatures of transposon-mediated genome inflation, host specialization, and photoentrainment in
eLife
·
20 May 2024
·
pmid:38767950

Epidemiological, clinical, and genomic landscape of coccidioidomycosis in northeastern Brazil.
Nature communications
·
12 Apr 2024
·
pmid:38609393

An endogenous DNA virus in an amphibian-killing fungus associated with pathogen genotype and virulence.
Current biology : CB
·
14 Mar 2024
·
pmid:38490202

Tracing histoplasmosis genomic epidemiology and species occurrence across the USA.
Emerging microbes & infections
·
11 Mar 2024
·
pmid:38465644

Class-wide genomic tendency throughout specific extremes in black fungi
Fungal Diversity
·
26 Feb 2024
·
doi:10.1007/s13225-024-00533-y

Draft genome sequence of a black yeast fungus
Exophiala xenobiotica
isolated from La Brea Tar Pits
Microbiology Resource Announcements
·
15 Feb 2024
·
doi:10.1128/mra.00913-23

Herptile gut microbiomes: a natural system to study multi-kingdom interactions between filamentous fungi and bacteria.
mSphere
·
13 Feb 2024
·
pmid:38349154

Whole community shotgun metagenomes of two biological soil crust types from the Mojave Desert.
Microbiology resource announcements
·
08 Feb 2024
·
pmid:38329355

Metagenomics untangles potential adaptations of Antarctic endolithic bacteria at the fringe of habitability.
The Science of the total environment
·
19 Jan 2024
·
pmid:38244622

Metatranscriptomes of two biological soil crust types from the Mojave desert in response to wetting.
Microbiology resource announcements
·
08 Jan 2024
·
pmid:38189307

Discovery of giant viruses as past and present infections of zoosporic fungi
openRxiv
·
05 Jan 2024
·
doi:10.1101/2024.01.04.574182

Fungi from Extreme Environments: Genome Sequences and Beyond
The Mycota
·
01 Jan 2024
·
doi:10.1007/978-3-031-75666-5_3
2023
Key processes required for the different stages of fungal carnivory by a nematode-trapping fungus.
PLoS biology
·
21 Nov 2023
·
pmid:37988381

The reference genome assembly of the bright cobblestone lichen, Acarospora socialis.
The Journal of heredity
·
15 Nov 2023
·
pmid:37740386

Evaluation of Different Gene Prediction Tools in Coccidioides immitis
Journal of Fungi
·
09 Nov 2023
·
doi:10.3390/jof9111094

Prevalence and diversity of TAL effector-like proteins in fungal endosymbiotic Mycetohabitans spp.
openRxiv
·
16 Oct 2023
·
doi:10.1101/2023.10.16.562584

Geographical survey of the mycobiome and microbiome of Southern California glassy-winged sharpshooters.
mSphere
·
06 Oct 2023
·
pmid:37800904

Genomic characterization and radiation tolerance of Naganishia kalamii sp. nov. and Cystobasidium onofrii sp. nov. from Mars 2020 mission assembly facilities.
IMA fungus
·
11 Aug 2023
·
pmid:37568226

Extremophilic and extremotolerant fungi.
Current biology : CB
·
24 Jul 2023
·
pmid:37490857

Sequencing the Genomes of the First Terrestrial Fungal Lineages: What Have We Learned?
Microorganisms
·
18 Jul 2023
·
pmid:37513002

Mrs4 loss of function in fungi during adaptation to the cystic fibrosis lung
mBio
·
11 Jul 2023
·
doi:10.1128/mbio.01171-23

Patterns and determinants of the global herbivorous mycobiome.
Nature communications
·
26 Jun 2023
·
pmid:37365172

Genomes of fungi and relatives reveal delayed loss of ancestral gene families and evolution of key fungal traits.
Nature ecology & evolution
·
22 Jun 2023
·
pmid:37349567

In host evolution of Exophiala dermatitidis in cystic fibrosis lung micro-environment
G3: Genes, Genomes, Genetics
·
09 Jun 2023
·
doi:10.1093/g3journal/jkad126

Genome Sequence of Lichtheimia ornata, an Emerging Opportunistic Mucorales Pathogen
Microbiology resource announcements
·
08 Jun 2023
·
pmid:37289095

Landscape characteristics shape surface soil microbiomes in the Chihuahuan Desert
Frontiers in Microbiology
·
07 Jun 2023
·
doi:10.3389/fmicb.2023.1135800

Highly diverse and unknown viruses may enhance Antarctic endoliths’ adaptability
Microbiome
·
08 May 2023
·
doi:10.1186/s40168-023-01554-6

Identification of the Neoaspergillic Acid Biosynthesis Gene Cluster by Establishing an In Vitro CRISPR-Ribonucleoprotein Genetic System in Aspergillus melleus
ACS omega
·
01 May 2023
·
pmid:37214671

Genome Sequence and Assembly of 18 Fusarium Isolates from Florida Citrus under High Huanglongbing Disease Pressure and California Citrus under Low Huanglongbing Disease Pressure.
Microbiology resource announcements
·
12 Apr 2023
·
pmid:37042758

Divergent Evolution of Early Terrestrial Fungi Reveals the Evolution of Mucormycosis Pathogenicity Factors.
Genome biology and evolution
·
06 Apr 2023
·
pmid:36930540

Microbiome diversity, composition and assembly in a California citrus orchard
Frontiers in Microbiology
·
22 Feb 2023
·
doi:10.3389/fmicb.2023.1100590

Comparative Genomic Analyses of Cellulolytic Machinery Reveal Two Nutritional Strategies of Marine Labyrinthulomycetes Protists.
Microbiology spectrum
·
06 Feb 2023
·
pmid:36744882
Phylogenomic analysis of the Neocallimastigomycota: proposal of Caecomycetaceae fam. nov., Piromycetaceae fam. nov., and emended description of the families Neocallimastigaceae and Anaeromycetaceae
International journal of systematic and evolutionary microbiology
·
01 Feb 2023
·
pmid:36827202

Mycoparasites, Gut Dwellers, and Saprotrophs: Phylogenomic Reconstructions and Comparative Analyses of Kickxellomycotina Fungi.
Genome biology and evolution
·
04 Jan 2023
·
pmid:36617272

Botrytis cinerea
small RNAs are associated with tomato AGO1 and silence tomato defense-related target genes supporting cross-kingdom RNAi
openRxiv
·
02 Jan 2023
·
doi:10.1101/2022.12.30.522274
2022

Description and Genome Characterization of Three Novel Fungal Strains Isolated from Mars 2020 Mission-Associated Spacecraft Assembly Facility Surfaces—Recommendations for Two New Genera and One Species
Journal of Fungi
·
23 Dec 2022
·
doi:10.3390/jof9010031

Cataloging Viral Diversity from Nonaxenic Terrestrial Cyanobacteria Cultures
openRxiv
·
14 Dec 2022
·
doi:10.1101/2022.12.14.520320

A single fungal strain was the unexpected cause of a mass aspergillosis outbreak in the world’s largest and only flightless parrot
iScience
·
01 Dec 2022
·
doi:10.1016/j.isci.2022.105470

The pan-genome of Aspergillus fumigatus provides a high-resolution view of its population structure revealing high levels of lineage-specific diversity driven by recombination
PLOS Biology
·
17 Nov 2022
·
doi:10.1371/journal.pbio.3001890

The future of fungi: threats and opportunities.
G3 (Bethesda, Md.)
·
04 Nov 2022
·
pmid:36179219

Transcriptome and population structure of glassy-winged sharpshooters (Homalodisca vitripennis) with varying insecticide resistance in southern California.
BMC genomics
·
22 Oct 2022
·
pmid:36273137

Manipulation of the Global Regulator mcrA Upregulates Secondary Metabolite Production in Aspergillus wentii Using CRISPR-Cas9 with In Vitro Assembled Ribonucleoproteins
ACS chemical biology
·
05 Oct 2022
·
pmid:36197945

Pan-cancer analyses reveal cancer-type-specific fungal ecologies and bacteriome interactions.
Cell
·
29 Sep 2022
·
pmid:36179670

Single nucleotide polymorphisms and chromosomal copy number variation may impact the Sporothrix brasiliensis antifungal susceptibility and sporotrichosis clinical outcomes.
Fungal genetics and biology : FG & B
·
21 Sep 2022
·
pmid:36152775

Diploid-dominant life cycles characterize the early evolution of Fungi.
Proceedings of the National Academy of Sciences of the United States of America
·
29 Aug 2022
·
pmid:36037379

Metagenome-Assembled Genomes of Bacteria Associated with Massospora cicadina Fungal Plugs from Infected Brood VIII Periodical Cicadas.
Microbiology resource announcements
·
29 Aug 2022
·
pmid:36036588

An Improved 1.5-Gigabase Draft Assembly of Massospora cicadina (Zoopagomycota), an Obligate Fungal Parasite of 13- and 17-Year Cicadas.
Microbiology resource announcements
·
29 Aug 2022
·
pmid:36036589

Comparative Genomics Reveals that Metabolism Underlies Evolution of Entomopathogenicity in Bee-loving Ascosphaera spp. Fungi
Journal of invertebrate pathology
·
03 Aug 2022
·
pmid:35933037

Evolution of zygomycete secretomes and the origins of terrestrial fungal ecologies
iScience
·
01 Aug 2022
·
doi:10.1016/j.isci.2022.104840

The Early Terrestrial Fungal Lineage of Conidiobolus - Transition from Saprotroph to Parasitic Lifestyle
Journal of fungi (Basel, Switzerland)
·
28 Jul 2022
·
pmid:36012777

The International Space Station Environment Triggers Molecular Responses in Aspergillus niger
Frontiers in microbiology
·
30 Jun 2022
·
pmid:35847112

Landscape Topography and Regional Drought Alters Dust Microbiomes in the Sierra Nevada of California.
Frontiers in microbiology
·
28 Jun 2022
·
pmid:35836417

The population genetics of the causative agent of snake fungal disease indicate recent introductions to the USA.
PLoS biology
·
23 Jun 2022
·
pmid:35737674

Metagenome-Assembled Genomes of Bacterial Symbionts Associated with Insecticide-Resistant and -Susceptible Individuals of the Glassy-Winged Sharpshooter (Homalodisca vitripennis).
Microbiology resource announcements
·
16 Jun 2022
·
pmid:35708345

Avian-associated Aspergillus fumigatus displays broad phylogenetic distribution, no evidence for host specificity, and multiple genotypes within epizootic events
G3 (Bethesda, Md.)
·
06 May 2022
·
pmid:35377435

Early branching arbuscular mycorrhizal fungus Paraglomus occultum carries a small and repeat-poor genome compared to relatives in the Glomeromycotina
Microbial Genomics
·
26 Apr 2022
·
doi:10.1099/mgen.0.000810

Efficient CRISPR/Cas9-mediated genome modification of the glassy-winged sharpshooter Homalodisca vitripennis (Germar)
Scientific reports
·
19 Apr 2022
·
pmid:35440677

A chromosomal-level reference genome of the widely utilized Coccidioides posadasii laboratory strain Silveira
G3 (Bethesda, Md.)
·
04 Apr 2022
·
pmid:35137016

Rocks support a distinctive and consistent mycobiome across contrasting dry regions of Earth.
FEMS microbiology ecology
·
31 Mar 2022
·
pmid:35298630

Fungi are key players in extreme ecosystems.
Trends in ecology & evolution
·
01 Mar 2022
·
pmid:35246323

Exploring Space via Astromycology A Report on the CIFAR Programs Earth 4D and Fungal Kingdom Inaugural Joint Meeting
Astrobiology
·
23 Feb 2022
·
pmid:35196462

Decoding Transcription Regulatory Mechanisms Associated with Coccidioides immitis Phase Transition Using Total RNA
mSystems
·
25 Jan 2022
·
pmid:35076277

Genomic Characterization of Parengyodontium torokii sp. nov., a Biofilm-Forming Fungus Isolated from Mars 2020 Assembly Facility
Journal of fungi (Basel, Switzerland)
·
09 Jan 2022
·
pmid:35050006
2021

Host Lung Environment Limits Aspergillus fumigatus Germination through an SskA-Dependent Signaling Response
mSphere
·
22 Dec 2021
·
doi:10.1128/msphere.00922-21

Understudied, underrepresented, and unknown: Methodological biases that limit detection of early diverging fungi from environmental samples
Molecular Ecology Resources
·
10 Nov 2021
·
doi:10.1111/1755-0998.13540

Crowdsourced analysis of fungal growth and branching on microfluidic platforms
PLOS ONE
·
29 Sep 2021
·
doi:10.1371/journal.pone.0257823

Improved draft reference genome for the Glassy-winged Sharpshooter (Homalodisca vitripennis), a vector for Pierce's disease.
G3 (Bethesda, Md.)
·
27 Sep 2021
·
pmid:34568917

Phylogenomic Analysis of a 55.1-kb 19-Gene Dataset Resolves a Monophyletic Fusarium that Includes the Fusarium solani Species Complex
Phytopathology
·
09 Sep 2021
·
pmid:33200960

Seven Years at High Salinity—Experimental Evolution of the Extremely Halotolerant Black Yeast Hortaea werneckii
Journal of Fungi
·
04 Sep 2021
·
doi:10.3390/jof7090723

Aspergillus fumigatus In-Host HOG Pathway Mutation for Cystic Fibrosis Lung Microenvironment Persistence
mBio
·
31 Aug 2021
·
doi:10.1128/mBio.02153-21

Mitochondrial genomes of the human pathogens Coccidioides immitis and Coccidioides posadasii.
G3 (Bethesda, Md.)
·
14 Jul 2021
·
pmid:33871031

Diploidy within a Haploid Genus of Entomopathogenic Fungi.
Genome biology and evolution
·
06 Jul 2021
·
pmid:34247231

Amplicon Sequencing of Rock-Inhabiting Microbial Communities from Joshua Tree National Park, USA.
Microbiology resource announcements
·
24 Jun 2021
·
pmid:34165331

Metagenome Sequencing to Explore Phylogenomics of Terrestrial Cyanobacteria
Microbiology Resource Announcements
·
03 Jun 2021
·
doi:10.1128/MRA.00258-21

High-Quality Reference Genome Sequence for the Oomycete Vegetable Pathogen Phytophthora capsici Strain LT1534.
Microbiology resource announcements
·
27 May 2021
·
pmid:34042486
Three species of Trimmatothelopsis (Acarosporaceae) from Europe and North America
The Bryologist
·
14 May 2021
·
doi:10.1639/0007-2745-124.2.271

Transcriptional Analysis of Coccidioides immitis Mycelia and Spherules by RNA Sequencing
Journal of fungi (Basel, Switzerland)
·
07 May 2021
·
pmid:34067070

Balancing Positive and Negative Selection - In Vivo Evolution of Candida lusitaniae MRR1
mBio
·
30 Mar 2021
·
pmid:33785623

Datura genome reveals duplications of psychoactive alkaloid biosynthetic genes and high mutation rate following tissue culture.
BMC genomics
·
22 Mar 2021
·
pmid:33752605

Pre-Cambrian roots of novel Antarctic cryptoendolithic bacterial lineages.
Microbiome
·
19 Mar 2021
·
pmid:33741058

Effects of Simulated Microgravity on the Proteome and Secretome of the Polyextremotolerant Black Fungus
Frontiers in genetics
·
18 Mar 2021
·
pmid:33815472

Culture-Dependent and Amplicon Sequencing Approaches Reveal Diversity and Distribution of Black Fungi in Antarctic Cryptoendolithic Communities.
Journal of fungi (Basel, Switzerland)
·
16 Mar 2021
·
pmid:33809619

Genomic insights into the host specific adaptation of the Pneumocystis genus.
Communications biology
·
08 Mar 2021
·
pmid:33686174

Identification and phylogenetic analysis of RNA binding domain abundant in apicomplexans or RAP proteins.
Microbial genomics
·
03 Mar 2021
·
pmid:33656416

A genome-scale phylogeny of the kingdom Fungi.
Current biology : CB
·
18 Feb 2021
·
pmid:33607033

Aspergillus fumigatus Strain-Specific Conidia Lung Persistence Causes an Allergic Broncho-Pulmonary Aspergillosis-Like Disease Phenotype.
mSphere
·
17 Feb 2021
·
pmid:33597172

A Heterogeneously Expressed Gene Family Modulates the Biofilm Architecture and Hypoxic Growth of Aspergillus fumigatus
mBio
·
16 Feb 2021
·
pmid:33593969

The genome of Geosiphon pyriformis reveals ancestral traits linked to the emergence of the arbuscular mycorrhizal symbiosis.
Current biology : CB
·
15 Feb 2021
·
pmid:33592192

Genomic analyses of two Italian oyster mushroom Pleurotus pulmonarius strains.
G3 (Bethesda, Md.)
·
09 Feb 2021
·
pmid:33585863

Genome sequence of the oyster mushroom Pleurotus ostreatus strain PC9.
G3 (Bethesda, Md.)
·
09 Feb 2021
·
pmid:33585864

Comparative genomics reveals dynamic genome evolution in host specialist ectomycorrhizal fungi.
The New phytologist
·
06 Feb 2021
·
pmid:33355923

Genome-scale phylogenetic analyses confirm Olpidium as the closest living zoosporic fungus to the non-flagellated, terrestrial fungi.
Scientific reports
·
05 Feb 2021
·
pmid:33547391
2020

Shed Light in the DaRk LineagES of the Fungal Tree of Life-STRES.
Life (Basel, Switzerland)
·
19 Dec 2020
·
pmid:33352712

A novel Sporothrix brasiliensis genomic variant in Midwestern Brazil evidence for an older and wider sporotrichosis epidemic
Emerging microbes & infections
·
01 Dec 2020
·
pmid:33155518

Beyond the extremes: Rocks as ultimate refuge for fungi in drylands.
Mycologia
·
24 Nov 2020
·
pmid:33232202

Clustering analysis of large-scale phenotypic data in the model filamentous fungus Neurospora crassa.
BMC genomics
·
02 Nov 2020
·
pmid:33138786

Belowground impacts of alpine woody encroachment are determined by plant traits, local climate, and soil conditions.
Global change biology
·
08 Oct 2020
·
pmid:32902066

Genomic diversity generated by a transposable element burst in a rice recombinant inbred population.
Proceedings of the National Academy of Sciences of the United States of America
·
05 Oct 2020
·
pmid:33020276

No to Neocosmospora- Phylogenomic and Practical Reasons for Continued Inclusion of the Fusarium solani Species Complex in the Genus Fusarium
mSphere
·
16 Sep 2020
·
pmid:32938701

Resolving the Mortierellaceae phylogeny through synthesis of multi-gene phylogenetics and phylogenomics.
Fungal diversity
·
16 Sep 2020
·
pmid:33364917

Survey of Early-Diverging Lineages of Fungi Reveals Abundant and Diverse Mycoviruses.
mBio
·
08 Sep 2020
·
pmid:32900807

Volatiles from Serratia marcescens, S. proteamaculans, and Bacillus subtilis Inhibit Growth of Rhizopus stolonifer and Other Fungi
openRxiv
·
07 Sep 2020
·
doi:10.1101/2020.09.07.286443

Best Practices for Successfully Writing and Publishing a Genome Announcement in Microbiology Resource Announcements
Microbiology resource announcements
·
03 Sep 2020
·
pmid:32883786

Phylogenomic Analyses of Non-Dikarya Fungi Supports Horizontal Gene Transfer Driving Diversification of Secondary Metabolism in the Amphibian Gastrointestinal Symbiont,
G3 (Bethesda, Md.)
·
02 Sep 2020
·
pmid:32727924

Insights into dryland biocrust microbiome: geography, soil depth and crust type affect biocrust microbial communities and networks in Mojave Desert, USA.
FEMS microbiology ecology
·
01 Sep 2020
·
pmid:32573682

Toward a Fully Resolved Fungal Tree of Life.
Annual review of microbiology
·
13 Jul 2020
·
pmid:32660385

Uncovered Microbial Diversity in Antarctic Cryptoendolithic Communities Sampling three Representative Locations of the Victoria Land.
Microorganisms
·
23 Jun 2020
·
pmid:32585947

Behavioral betrayal: How select fungal parasites enlist living insects to do their bidding.
PLoS pathogens
·
18 Jun 2020
·
pmid:32555716

Evolutionary relationships among
Mycologia
·
15 May 2020
·
pmid:32412847

Threats Posed by the Fungal Kingdom to Humans, Wildlife, and Agriculture.
mBio
·
05 May 2020
·
pmid:32371596

Draft Genome Sequence of the Yeast Rhodotorula sp. strain CCFEE 5036, Isolated from McMurdo Dry Valleys, Antarctica
Microbiology resource announcements
·
02 Apr 2020
·
pmid:32241854

Natural diversity in the predatory behavior facilitates the establishment of a robust model strain for nematode-trapping fungi.
Proceedings of the National Academy of Sciences of the United States of America
·
11 Mar 2020
·
pmid:32161129

Metagenomes in the Borderline Ecosystems of the Antarctic Cryptoendolithic Communities.
Microbiology resource announcements
·
05 Mar 2020
·
pmid:32139564

Endolithic Fungal Species Markers for Harshest Conditions in the McMurdo Dry Valleys, Antarctica.
Life (Basel, Switzerland)
·
06 Feb 2020
·
pmid:32041249

Peculiar genomic traits in the stress-adapted cryptoendolithic Antarctic fungus Friedmanniomyces endolithicus.
Fungal biology
·
31 Jan 2020
·
pmid:32389308

The monophyletic Sarcogyne canadensis–wheeleri clade, a newly recognized group sister to the European Acarospora glaucocarpa group
The Bryologist
·
13 Jan 2020
·
doi:10.1639/0007-2745-123.1.011

Airborne fungi spores distribution in various locations in Lagos, Nigeria.
Environmental monitoring and assessment
·
03 Jan 2020
·
pmid:31900675
2019
Probe-Based Multiplex Real-Time PCR as a Diagnostic Tool to Distinguish Distinct Fungal Symbionts Associated With
Plant disease
·
23 Oct 2019
·
pmid:31647694

Reproduction and Dispersal of Biological Soil Crust Organisms
Frontiers in Ecology and Evolution
·
04 Oct 2019
·
doi:10.3389/fevo.2019.00344

Microfluidics and Metabolomics Reveal Symbiotic Bacterial-Fungal Interactions Between Mortierella elongata and Burkholderia Include Metabolite Exchange
Frontiers in microbiology
·
01 Oct 2019
·
pmid:31632357

Fungal biofilm morphology impacts hypoxia fitness and disease progression.
Nature microbiology
·
23 Sep 2019
·
pmid:31548684

Members of the Euwallacea fornicatus species complex exhibit promiscuous mutualism with ambrosia fungi in Taiwan.
Fungal genetics and biology : FG & B
·
10 Sep 2019
·
pmid:31518652

Future-Proofing Your Microbiology Resource Announcements Genome Assembly for Reproducibility and Clarity
Microbiology resource announcements
·
05 Sep 2019
·
pmid:31488541
Molecular Dating of the Emergence of Anaerobic Rumen Fungi and the Impact of Laterally Acquired Genes.
mSystems
·
27 Aug 2019
·
pmid:31455637

Altitude and fungal diversity influence the structure of Antarctic cryptoendolithic Bacteria communities.
Environmental microbiology reports
·
26 Aug 2019
·
pmid:31393667
Improved Reference Genome Sequence of Coccidioides immitis Strain WA_211, Isolated in Washington State
Microbiology resource announcements
·
15 Aug 2019
·
pmid:31416856
Horizontal Gene Transfer as an Indispensable Driver for Evolution of Neocallimastigomycota into a Distinct Gut-Dwelling Fungal Lineage.
Applied and environmental microbiology
·
18 Jul 2019
·
pmid:31126947
Diversity and function of fungi associated with the fungivorous millipede, Brachycybe lecontii
Fungal ecology
·
09 Jul 2019
·
pmid:31871487
Psychoactive plant- and mushroom-associated alkaloids from two behavior modifying cicada pathogens.
Fungal ecology
·
24 Jun 2019
·
pmid:31768192
Proteomic and Metabolomic Characteristics of Extremophilic Fungi Under Simulated Mars Conditions.
Frontiers in microbiology
·
15 May 2019
·
pmid:31156574

Draft Genome Sequence of an Antarctic Isolate of the Black Yeast Fungus Exophiala mesophila
Microbiology resource announcements
·
09 May 2019
·
pmid:31072892

FGMP: assessing fungal genome completeness.
BMC bioinformatics
·
15 Apr 2019
·
pmid:30987585

Fungi in the Marine Environment: Open Questions and Unsolved Problems.
mBio
·
05 Mar 2019
·
pmid:30837337

Diversity of cytosine methylation across the fungal tree of life.
Nature ecology & evolution
·
18 Feb 2019
·
pmid:30778188

Tracking the origin of two genetic components associated with transposable element bursts in domesticated rice.
Nature communications
·
07 Feb 2019
·
pmid:30733435
Pyricularia graminis-tritici is not the correct species name for the wheat blast fungus: response to Ceresini et al. (MPP 20:2).
Molecular plant pathology
·
01 Feb 2019
·
pmid:30697917

Genome Sequence of a Lethal Vascular Wilt Fungus, Verticillium nonalfalfae, a Biological Control Used Against the Invasive Ailanthus altissima.
Microbiology resource announcements
·
24 Jan 2019
·
pmid:30701257

Phylogenomics of Endogonaceae and evolution of mycorrhizas within Mucoromycota.
The New phytologist
·
12 Jan 2019
·
pmid:30485448

Genome-scale phylogenetics reveals a monophyletic Zoopagales (Zoopagomycota, Fungi).
Molecular phylogenetics and evolution
·
11 Jan 2019
·
pmid:30639767
2018

International Space Station conditions alter genomics, proteomics, and metabolomics in Aspergillus nidulans.
Applied microbiology and biotechnology
·
12 Dec 2018
·
pmid:30539259

Evolution of drug resistance in an antifungal-naive chronic
Proceedings of the National Academy of Sciences of the United States of America
·
02 Nov 2018
·
pmid:30389707
Parasitoid Jewel Wasp Mounts Multipronged Neurochemical Attack to Hijack a Host Brain.
Molecular & cellular proteomics : MCP
·
06 Oct 2018
·
pmid:30293061
Early Diverging Insect-Pathogenic Fungi of the Order Entomophthorales Possess Diverse and Unique Subtilisin-Like Serine Proteases.
G3 (Bethesda, Md.)
·
03 Oct 2018
·
pmid:30111619
Characterization of Aspergillus niger Isolated from the International Space Station.
mSystems
·
18 Sep 2018
·
pmid:30246146
Comparative analysis reveals unexpected genome features of newly isolated Thraustochytrids strains: on ecological function and PUFAs biosynthesis.
BMC genomics
·
17 Jul 2018
·
pmid:30016947
Antarctic Cryptoendolithic Fungal Communities Are Highly Adapted and Dominated by Lecanoromycetes and Dothideomycetes.
Frontiers in microbiology
·
29 Jun 2018
·
pmid:30008702
Sun Exposure Shapes Functional Grouping of Fungi in Cryptoendolithic Antarctic Communities.
Life (Basel, Switzerland)
·
02 Jun 2018
·
pmid:29865244

Phylogenetic and Phylogenomic Definition of Rhizopus Species
G3 (Bethesda, Md.)
·
31 May 2018
·
pmid:29674435
Genomic evidence for intraspecific hybridization in a clonal and extremely halotolerant yeast.
BMC genomics
·
15 May 2018
·
pmid:29764372
Comparative Genomics Reveals the Core Gene Toolbox for the Fungus-Insect Symbiosis.
mBio
·
15 May 2018
·
pmid:29764946
Shrub range expansion alters diversity and distribution of soil fungal communities across an alpine elevation gradient.
Molecular ecology
·
10 May 2018
·
pmid:29675967
Comparative Population Genomics Analysis of the Mammalian Fungal Pathogen
mBio
·
08 May 2018
·
pmid:29739910
Ultra-low input transcriptomics reveal the spore functional content and phylogenetic affiliations of poorly studied arbuscular mycorrhizal fungi.
DNA research : an international journal for rapid publication of reports on genes and genomes
·
01 Apr 2018
·
pmid:29211832
Analysis of Transposable Elements in Coccidioides Species.
Journal of fungi (Basel, Switzerland)
·
19 Jan 2018
·
pmid:29371508
Comparative genomic analysis of the 'pseudofungus'
Open biology
·
01 Jan 2018
·
pmid:29321239
2017
Tracking the genome-wide outcomes of a transposable element burst over decades of amplification.
Proceedings of the National Academy of Sciences of the United States of America
·
20 Nov 2017
·
pmid:29158416
Chlorophyte aspartyl aminopeptidases: Ancient origins, expanded families, new locations, and secondary functions.
PloS one
·
12 Oct 2017
·
pmid:29023459
Microbial associates of the southern mole cricket (Scapteriscus borellii) are highly pathogenic.
Journal of invertebrate pathology
·
12 Sep 2017
·
pmid:28916147
The Fungal Tree of Life: from Molecular Systematics to Genome-Scale Phylogenies.
Microbiology spectrum
·
01 Sep 2017
·
pmid:28917057
Bifiguratus adelaidae, gen. et sp. nov., a new member of Mucoromycotina in endophytic and soil-dwelling habitats.
Mycologia
·
08 Aug 2017
·
pmid:28876195
Draft Genome Sequences of the Antarctic Endolithic Fungi Rachicladosporium antarcticum CCFEE 5527 and Rachicladosporium sp. CCFEE 5018
Genome announcements
·
06 Jul 2017
·
pmid:28684563
Insight into the Recent Genome Duplication of the Halophilic Yeast
G3 (Bethesda, Md.)
·
05 Jul 2017
·
pmid:28500048
Fungal Genomes and Insights into the Evolution of the Kingdom.
Microbiology spectrum
·
01 Jul 2017
·
pmid:28820125
Widespread adenine N6-methylation of active genes in fungi.
Nature genetics
·
08 May 2017
·
pmid:28481340
Exploring the binding properties and structural stability of an opsin in the chytrid
PeerJ
·
27 Apr 2017
·
pmid:28462022
Innovation and constraint leading to complex multicellularity in the Ascomycota.
Nature communications
·
08 Feb 2017
·
pmid:28176784
RelocaTE2: a high resolution transposable element insertion site mapping tool for population resequencing.
PeerJ
·
26 Jan 2017
·
pmid:28149701
2016

PCR Multiplexes Discriminate Fusarium Symbionts of Invasive Euwallacea Ambrosia Beetles that Inflict Damage on Numerous Tree Species Throughout the United States.
Plant disease
·
01 Nov 2016
·
pmid:30682305

A phylum-level phylogenetic classification of zygomycete fungi based on genome-scale data.
Mycologia
·
01 Sep 2016
·
pmid:27738200

Fungal Evolution: Mucor and Phycomyces See Double.
Current biology : CB
·
22 Aug 2016
·
pmid:27554660

Transposable Elements versus the Fungal Genome: Impact on Whole-Genome Architecture and Transcriptional Profiles.
PLoS genetics
·
13 Jun 2016
·
pmid:27294409

Deacetylation of Fungal Exopolysaccharide Mediates Adhesion and Biofilm Formation.
mBio
·
05 Apr 2016
·
pmid:27048799

Small genome of the fungus Escovopsis weberi, a specialized disease agent of ant agriculture.
Proceedings of the National Academy of Sciences of the United States of America
·
14 Mar 2016
·
pmid:26976598

Contributions of North American endophytes to the phylogeny, ecology, and taxonomy of Xylariaceae (Sordariomycetes, Ascomycota).
Molecular phylogenetics and evolution
·
20 Feb 2016
·
pmid:26903035
2015

Meeting Report: Fungal Genomics Meets Social Media: Highlights of the 28th Fungal Genetics Conference at Asilomar.
G3 (Bethesda, Md.)
·
01 Dec 2015
·
pmid:27034999

Cellular Subcompartments through Cytoplasmic Streaming.
Developmental cell
·
24 Aug 2015
·
pmid:26305593

Endogenous Small RNA Mediates Meiotic Silencing of a Novel DNA Transposon.
G3 (Bethesda, Md.)
·
23 Jun 2015
·
pmid:26109355
Characterization of the Carbohydrate Binding Module 18 gene family in the amphibian pathogen Batrachochytrium dendrobatidis.
Fungal genetics and biology : FG & B
·
25 Mar 2015
·
pmid:25819009

The low information content of Neurospora splicing signals: implications for RNA splicing and intron origin.
RNA (New York, N.Y.)
·
24 Mar 2015
·
pmid:25805857

Analysis of the Candida albicans Phosphoproteome.
Eukaryotic cell
·
06 Mar 2015
·
pmid:25750214
Twenty-first century mycology: a diverse, collaborative, and highly relevant science.
The New phytologist
·
01 Jan 2015
·
pmid:25427217
2014
Comparative genomics of the major fungal agents of human and animal Sporotrichosis: Sporothrix schenckii and Sporothrix brasiliensis.
BMC genomics
·
29 Oct 2014
·
pmid:25351875

MicroRNAs suppress NB domain genes in tomato that confer resistance to Fusarium oxysporum.
PLoS pathogens
·
16 Oct 2014
·
pmid:25330340

Deciphering the uniqueness of Mucoromycotina cell walls by combining biochemical and phylogenomic approaches.
Environmental microbiology
·
22 Sep 2014
·
pmid:25143134

Evolutionary histories of soil fungi are reflected in their large-scale biogeography.
Ecology letters
·
09 Jun 2014
·
pmid:24912000

Literature-based gene curation and proposed genetic nomenclature for cryptococcus.
Eukaryotic cell
·
09 May 2014
·
pmid:24813190

Analysis of the genome and transcriptome of Cryptococcus neoformans var. grubii reveals complex RNA expression and microevolution leading to virulence attenuation.
PLoS genetics
·
17 Apr 2014
·
pmid:24743168
2013

Evolutionary origins and diversification of proteobacterial mutualists.
Proceedings. Biological sciences
·
27 Nov 2013
·
pmid:24285193
MIxS-BE: a MIxS extension defining a minimum information standard for sequence data from the built environment.
The ISME journal
·
24 Oct 2013
·
pmid:24152717

The genome and development-dependent transcriptomes of Pyronema confluens: a window into fungal evolution.
PLoS genetics
·
19 Sep 2013
·
pmid:24068976
Toward genome-enabled mycology.
Mycologia
·
08 Aug 2013
·
pmid:23928422
Shared signatures of parasitism and phylogenomics unite Cryptomycota and microsporidia.
Current biology : CB
·
08 Aug 2013
·
pmid:23932404

Sequential utilization of hosts from different fly families by genetically distinct, sympatric populations within the Entomophthora muscae species complex.
PloS one
·
08 Aug 2013
·
pmid:23951101

Neurospora and the dead-end hypothesis: genomic consequences of selfing in the model genus.
Evolution; international journal of organic evolution
·
05 Aug 2013
·
pmid:24299411
The use of RelocaTE and unassembled short reads to produce high-resolution snapshots of transposable element generated diversity in rice.
G3 (Bethesda, Md.)
·
21 Jun 2013
·
pmid:23576519
Complex history of the amphibian-killing chytrid fungus revealed with genome resequencing data.
Proceedings of the National Academy of Sciences of the United States of America
·
06 May 2013
·
pmid:23650365
Meeting report: fungal its workshop (october 2012).
Standards in genomic sciences
·
15 Apr 2013
·
pmid:23961317
Regional control of histone H3 lysine 27 methylation in Neurospora.
Proceedings of the National Academy of Sciences of the United States of America
·
25 Mar 2013
·
pmid:23530226
5'-Serial Analysis of Gene Expression studies reveal a transcriptomic switch during fruiting body development in Coprinopsis cinerea.
BMC genomics
·
20 Mar 2013
·
pmid:23514374
Genomic insights into the atopic eczema-associated skin commensal yeast Malassezia sympodialis.
mBio
·
22 Jan 2013
·
pmid:23341551
2012
Analyses of expressed sequence tags in Neurospora reveal rapid evolution of genes associated with the early stages of sexual reproduction in fungi.
BMC evolutionary biology
·
27 Nov 2012
·
pmid:23186325
Species-specific chitin-binding module 18 expansion in the amphibian pathogen Batrachochytrium dendrobatidis.
mBio
·
19 Jun 2012
·
pmid:22718849
Unidirectional evolutionary transitions in fungal mating systems and the role of transposable elements.
Molecular biology and evolution
·
15 May 2012
·
pmid:22593224
2011
FungiDB: an integrated functional genomics database for fungi.
Nucleic acids research
·
07 Nov 2011
·
pmid:22064857
Genomic transition to pathogenicity in chytrid fungi.
PLoS pathogens
·
03 Nov 2011
·
pmid:22072962
Massive changes in genome architecture accompany the transition to self-fertility in the filamentous fungus Neurospora tetrasperma.
Genetics
·
12 Jul 2011
·
pmid:21750257
Genome variation in Cryptococcus gattii, an emerging pathogen of immunocompetent hosts.
mBio
·
08 Feb 2011
·
pmid:21304167
2010
A molecular perspective: biology of the emerging pathogen Batrachochytrium dendrobatidis.
Diseases of aquatic organisms
·
01 Nov 2010
·
pmid:21268975
Analysis of the Basidiomycete Coprinopsis cinerea reveals conservation of the core meiotic expression program over half a billion years of evolution.
PLoS genetics
·
23 Sep 2010
·
pmid:20885784
Using the Generic Synteny Browser (GBrowse_syn).
Current protocols in bioinformatics
·
01 Sep 2010
·
pmid:20836076
Transcription factors in light and circadian clock signaling networks revealed by genomewide mapping of direct targets for neurospora white collar complex.
Eukaryotic cell
·
30 Jul 2010
·
pmid:20675579
Genome sequence of the necrotrophic plant pathogen Pythium ultimum reveals original pathogenicity mechanisms and effector repertoire.
Genome biology
·
13 Jul 2010
·
pmid:20626842
Genome sequence of the model mushroom Schizophyllum commune.
Nature biotechnology
·
11 Jul 2010
·
pmid:20622885
Conflict between reproductive gene trees and species phylogeny among heterothallic and pseudohomothallic members of the filamentous ascomycete genus Neurospora.
Fungal genetics and biology : FG & B
·
01 Jul 2010
·
pmid:20601044
Insights into evolution of multicellular fungi from the assembled chromosomes of the mushroom Coprinopsis cinerea (Coprinus cinereus).
Proceedings of the National Academy of Sciences of the United States of America
·
14 Jun 2010
·
pmid:20547848
Population genomic sequencing of Coccidioides fungi reveals recent hybridization and transposon control.
Genome research
·
01 Jun 2010
·
pmid:20516208
De novo assembly of a 40 Mb eukaryotic genome from short sequence reads: Sordaria macrospora, a model organism for fungal morphogenesis.
PLoS genetics
·
08 Apr 2010
·
pmid:20386741
The deadly chytrid fungus: a story of an emerging pathogen.
PLoS pathogens
·
29 Jan 2010
·
pmid:20126439
2009
The fungi.
Current biology : CB
·
29 Sep 2009
·
pmid:19788875
Comparative genomic analyses of the human fungal pathogens Coccidioides and their relatives.
Genome research
·
28 Aug 2009
·
pmid:19717792
Proteomic and phenotypic profiling of the amphibian pathogen Batrachochytrium dendrobatidis shows that genotype is linked to virulence.
Molecular ecology
·
01 Feb 2009
·
pmid:19161465
2008
Resolving arthropod phylogeny: exploring phylogenetic signal within 41 kb of protein-coding nuclear gene sequence.
Systematic biology
·
01 Dec 2008
·
pmid:19085333
Global gene expression profiles for life stages of the deadly amphibian pathogen Batrachochytrium dendrobatidis.
Proceedings of the National Academy of Sciences of the United States of America
·
13 Oct 2008
·
pmid:18852473
The genome of Laccaria bicolor provides insights into mycorrhizal symbiosis.
Nature
·
06 Mar 2008
·
pmid:18322534
Comparative hybridization reveals extensive genome variation in the AIDS-associated pathogen Cryptococcus neoformans.
Genome biology
·
22 Feb 2008
·
pmid:18294377
2007
An expanded family of fungalysin extracellular metallopeptidases of Coprinopsis cinerea.
Mycological research
·
14 Dec 2007
·
pmid:18313909
Evolution of the mating type locus: insights gained from the dimorphic primary fungal pathogens Histoplasma capsulatum, Coccidioides immitis, and Coccidioides posadasii.
Eukaryotic cell
·
02 Mar 2007
·
pmid:17337636
Evolution of budding yeast prion-determinant sequences across diverse fungi.
Journal of molecular biology
·
03 Feb 2007
·
pmid:17320905
Comparative genomic analysis of fungal genomes reveals intron-rich ancestors.
Genome biology
·
01 Jan 2007
·
pmid:17949488
An Introduction to BioPerl.
Methods in molecular biology (Clifton, N.J.)
·
01 Jan 2007
·
pmid:18287711
2006
The evolution of mammalian gene families.
PloS one
·
20 Dec 2006
·
pmid:17183716
BASC: an integrated bioinformatics system for Brassica research.
Nucleic acids research
·
05 Dec 2006
·
pmid:17148473
A fungal phylogeny based on 42 complete genomes derived from supertree and combined gene analysis.
BMC evolutionary biology
·
22 Nov 2006
·
pmid:17121679
Insights from the genome of the biotrophic fungal plant pathogen Ustilago maydis.
Nature
·
02 Nov 2006
·
pmid:17080091
Reconstructing the early evolution of Fungi using a six-gene phylogeny.
Nature
·
19 Oct 2006
·
pmid:17051209
The Cryptococcus neoformans catalase gene family and its role in antioxidant defense.
Eukaryotic cell
·
01 Sep 2006
·
pmid:16963629
Open source tools and toolkits for bioinformatics: significance, and where are we?
Briefings in bioinformatics
·
09 Aug 2006
·
pmid:16899494
Phylogenomic analysis of non-ribosomal peptide synthetases in the genus Aspergillus.
Gene
·
21 Jul 2006
·
pmid:16962256
Evidence of mRNA-mediated intron loss in the human-pathogenic fungus Cryptococcus neoformans.
Eukaryotic cell
·
01 May 2006
·
pmid:16682456
Comparative analysis of Saccharomyces cerevisiae WW domains and their interacting proteins.
Genome biology
·
10 Apr 2006
·
pmid:16606443
Comparative genomics in C. elegans, C. briggsae, and other Caenorhabditis species.
Methods in molecular biology (Clifton, N.J.)
·
01 Jan 2006
·
pmid:16988423
2005
Same-sex mating and the origin of the Vancouver Island Cryptococcus gattii outbreak.
Nature
·
09 Oct 2005
·
pmid:16222245
Likelihoods from summary statistics: recent divergence between species.
Genetics
·
02 Sep 2005
·
pmid:16143628
Estimating the tempo and mode of gene family evolution from comparative genomic data.
Genome research
·
01 Aug 2005
·
pmid:16077014
Investigating hookworm genomes by comparative analysis of two Ancylostoma species.
BMC genomics
·
26 Apr 2005
·
pmid:15854223
2004
Identification of Cryptococcus neoformans temperature-regulated genes with a genomic-DNA microarray.
Eukaryotic cell
·
01 Oct 2004
·
pmid:15470254
Disentangling the effects of demography and selection in human history.
Molecular biology and evolution
·
08 Sep 2004
·
pmid:15356276
2003
The genome sequence of Caenorhabditis briggsae: a platform for comparative genomics.
PLoS biology
·
17 Nov 2003
·
pmid:14624247
The effects of selection against spurious transcription factor binding sites.
Molecular biology and evolution
·
25 Apr 2003
·
pmid:12716998
2002
The generic genome browser: a building block for a model organism system database.
Genome research
·
01 Oct 2002
·
pmid:12368253
The Bioperl toolkit: Perl modules for the life sciences.
Genome research
·
01 Oct 2002
·
pmid:12368254
2001
Ganglioside-induced differentiation-associated protein-1 is mutant in Charcot-Marie-Tooth disease type 4A/8q21.
Nature genetics
·
17 Dec 2001
·
pmid:11743579

